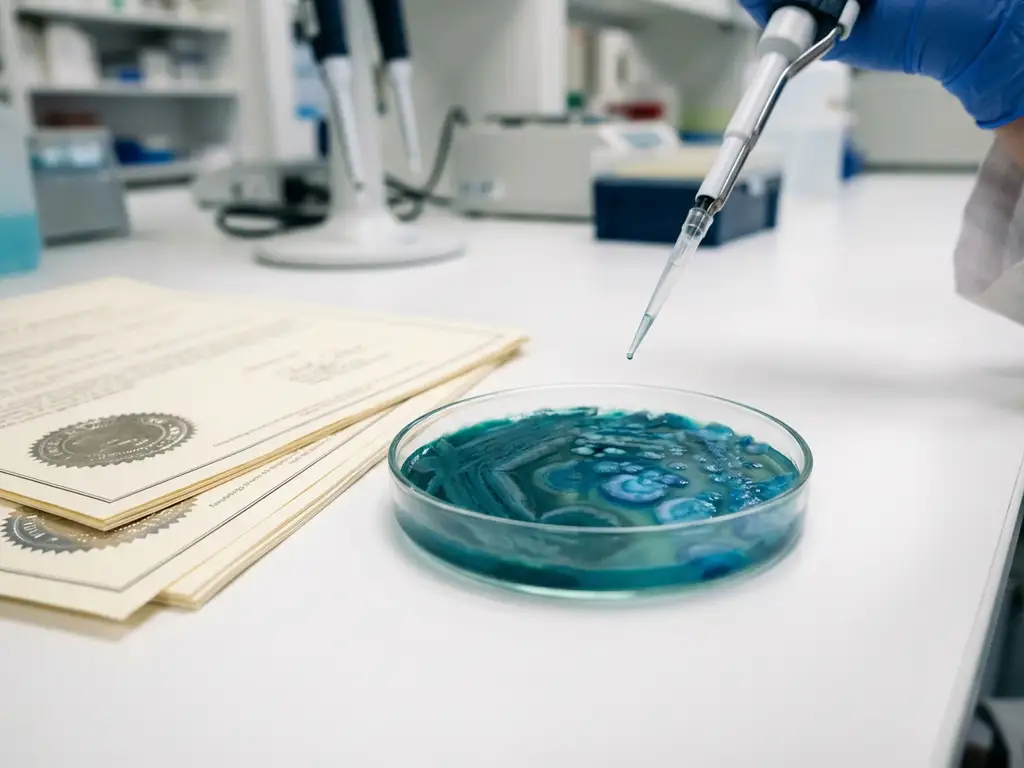
Scientist with pipette examining colorful teal and blue bacterial colonies in petri dish on laboratory bench with regulatory documents

Gut microbiome tests provide crucial mechanistic evidence and predictive data that regulatory agencies increasingly require for product approval. Modern regulatory frameworks demand validated preclinical models that can predict clinical outcomes, assess safety profiles, and demonstrate mode-of-action evidence. This comprehensive guide addresses the most critical questions about using gut microbiome testing to strengthen regulatory submissions and accelerate approval timelines.
What evidence do regulatory agencies require for gut microbiome products?
Regulatory agencies such as the FDA, EFSA, and Health Canada require comprehensive mechanistic data, mode-of-action evidence, and safety documentation for microbiome-based products. They demand validated preclinical studies that demonstrate causal relationships rather than simple correlations, along with population-specific response profiles and dose-response relationships.
The regulatory landscape has shifted dramatically toward requiring predictive preclinical evidence. Agencies now expect detailed documentation of how products modulate specific microbial populations, the resulting metabolic changes, and their physiological impact on host systems. This includes safety assessments across diverse populations, data on inter-individual variability, and mechanistic insights into product efficacy.
Modern regulatory submissions must demonstrate that products work through validated biological pathways. This requires sophisticated testing methodologies that can accurately predict human responses while providing the depth of mechanistic understanding necessary for health-claim substantiation and regulatory approval.
How do preclinical gut microbiome tests predict clinical outcomes?
Advanced ex vivo gut simulation technologies bridge the gap between basic laboratory testing and expensive clinical trials by maintaining the original donor microbiome composition throughout testing. These validated platforms can predict individual responses, dose-response relationships, and mechanisms of action with clinical relevance within 24–48 hours.
The key lies in capturing immediate microbiome modulation effects that occur within hours of exposure. Gut bacteria respond rapidly to environmental changes, altering their growth rates and metabolic activity almost immediately. These rapid primary microbial responses are the causal events that initiate host responses and drive longer-term clinical benefits.
Validated ex vivo technologies preserve both the taxonomic and functional characteristics of fresh human microbiota. This biological relevance enables accurate prediction of how different populations will respond to interventions, supports the development of personalized nutrition strategies, and reduces clinical trial failure rates through better preclinical screening.
What’s the difference between traditional testing and validated gut microbiome simulation?
Traditional in vitro models and animal studies suffer from significant limitations, including poor human relevance, selection bias, and an inability to capture population diversity. Validated ex vivo gut simulation platforms maintain physiological relevance by preserving the original microbiome composition and simulating real gut environmental conditions.
Animal models have fundamental limitations for human gut microbiome research. Animal microbiomes differ taxonomically and functionally from human microbiomes and involve different digestive physiology, gut transit times, pH levels, and bile acid profiles. These differences lead to non-translatable results that do not accurately predict human responses.
Sophisticated ex vivo platforms overcome these limitations by using fresh, unmodified human microbiota and maintaining appropriate pH levels, oxygen conditions, and nutrient availability. This approach enables testing across diverse human populations, including different age groups and disease states, while providing the high throughput necessary for comprehensive product evaluation.
Why do so many microbiome products fail during regulatory review?
Common regulatory failure points include insufficient mechanistic evidence, a lack of inter-individual variability data, inadequate safety documentation, and poor translation from preclinical to clinical results. This creates the notorious “Valley of Death” between promising laboratory results and successful regulatory approval.
Many products fail because traditional preclinical models do not accurately predict human responses. Simple in vitro tests miss the complexity of real gut environments, while animal studies provide misleading data due to fundamental physiological differences. Without validated preclinical evidence, products often fail in expensive clinical trials, resulting in massive financial losses.
Regulatory agencies increasingly demand evidence of how products work across diverse populations. Products that show promise in basic laboratory tests often fail when exposed to real-world human variability. The lack of responder-versus-non-responder profiling and population-specific efficacy data contributes significantly to regulatory rejection rates.
How can companies build stronger regulatory dossiers for microbiome products?
Building robust regulatory dossiers requires validated preclinical data, comprehensive mechanistic evidence, detailed safety profiles, and population-specific response documentation. Companies should prioritize predictive preclinical testing that correlates directly with clinical outcomes and provides the depth of evidence regulatory bodies require.
Successful regulatory submissions include dose-response relationships, inter-individual variability assessments, and mechanistic insights into mode of action. This requires testing across diverse donor populations, with a minimum of 6–8 donors per cohort, to capture human microbiome variability and identify responder profiles.
Documentation should demonstrate both immediate microbiome modulation effects and their relationship to longer-term health outcomes. Regulatory bodies value an evidence hierarchy that shows causal relationships between product intervention, microbial changes, metabolic shifts, and physiological benefits through validated testing methodologies.
How Cryptobiotix helps with regulatory approval preparation
Cryptobiotix provides validated, predictive insights for regulatory dossiers through our proprietary SIFR® technology platform. Our ex vivo gut simulation technology delivers clinically predictive data within days, addressing the Valley of Death between preclinical and clinical research with proven correlation to human outcomes.
Our comprehensive regulatory support services include:
- Mechanistic studies demonstrating mode-of-action evidence
- Dose-response analysis across diverse human populations
- Safety assessment and tolerability profiling
- Inter-individual variability analysis with responder identification
- Host–microbiome interaction studies using validated cell models
- Population-specific testing for targeted demographics
We support companies across multiple sectors, including functional foods, pharmaceuticals, and biotechnology, with validated preclinical evidence that regulatory agencies accept. Our scientific publications demonstrate proven clinical predictivity for taxonomy, metabolomics, and tolerability outcomes.
Ready to strengthen your regulatory submission with validated gut microbiome testing? Contact our regulatory support team to discuss how SIFR® technology can de-risk your product development and accelerate regulatory approval.
Frequently Asked Questions
How long does it typically take to generate regulatory-grade data using ex vivo gut microbiome testing?
Ex vivo gut simulation platforms can generate comprehensive regulatory data within 24-48 hours for initial screening, with complete mechanistic studies typically completed within 2-4 weeks. This dramatically accelerates the preclinical phase compared to traditional animal studies that can take months, allowing companies to iterate quickly on formulations and build stronger regulatory dossiers before moving to expensive clinical trials.
What's the minimum sample size needed to demonstrate population diversity for regulatory submissions?
Regulatory agencies typically expect data from at least 6-8 diverse donors per demographic cohort to capture meaningful inter-individual variability. For comprehensive population coverage, companies should test across different age groups, ethnicities, and health states relevant to their target market. This approach helps identify responder versus non-responder profiles that regulatory bodies increasingly require for approval.
Can ex vivo testing results directly replace animal studies in regulatory submissions?
While ex vivo gut simulation provides more human-relevant data than animal studies, regulatory requirements vary by jurisdiction and product type. Many agencies are increasingly accepting validated ex vivo data as primary evidence, especially when combined with appropriate safety studies. The key is demonstrating that your ex vivo platform has been validated against clinical outcomes and provides mechanistically relevant data that animal models cannot deliver.
What are the most common mistakes companies make when preparing microbiome regulatory dossiers?
The biggest mistakes include relying solely on correlative data without mechanistic evidence, using oversimplified in vitro models that don't reflect gut complexity, and failing to address inter-individual variability. Many companies also underestimate the importance of dose-response relationships and population-specific efficacy data. Starting with validated preclinical testing early in development helps avoid these costly pitfalls.
How do regulatory agencies evaluate the clinical predictivity of preclinical microbiome data?
Agencies assess whether preclinical models accurately predict human responses by examining validation studies that compare preclinical results to actual clinical outcomes. They look for demonstrated correlations between ex vivo findings and human trial data, including taxonomy changes, metabolite profiles, and safety parameters. Platforms with published validation studies showing clinical predictivity carry significantly more regulatory weight than unvalidated testing methods.